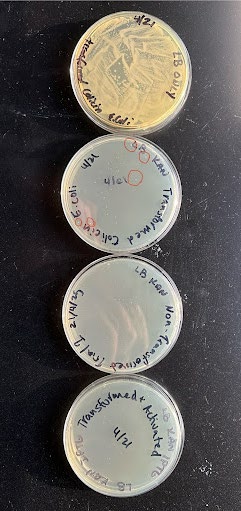
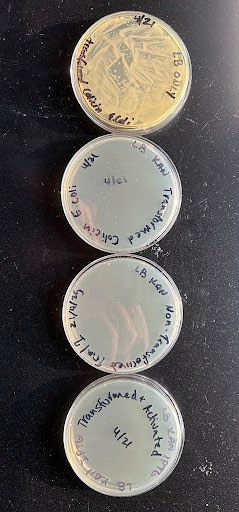

Graham Harris, Nathan Kralik, Audrey J. Latham, Ava M. Lebovitz, Lincoln Lundak, Linnea Nam, Keaton Roberts, Charlie Scott, River Scott, and Lily Zinthefer, Oak Park, Oak Park and River Forest High School, Oak Park, Illinois, United States
Reviewed on 3 May 2025; Accepted on 9 June 2025; Published on 27 October 2025
With help from the 2025 BioTreks Production Team.
Escherichia coli is a cause of foodborne illness, and the emergence of antibiotic-resistant strains poses significant risks to food safety, public health, and hospital infection control. With traditional antibiotics losing efficacy, new antimicrobial strategies are needed. This study explores colicin-based biocontrol as a potential solution. We engineered a plasmid that enables E. coli K-12 to produce Colicin V, a toxin targeting other antibiotic-resistant E. coli strains that carry a colicin resistance gene, thereby preventing it from targeting itself. The plasmid also codes for Kanamycin resistance. To assess its efficacy, we will conduct LB agar plate assays under three conditions: (1) Transformed E. coli with just LB agar to assess E. coli growth; (2) transformed E. coli with LB Agar and Kanamycin to assess plasmid uptake and resistance to Kanamycin; (3) non-transformed E. coli with LB Agar and Kanamycin to assess the effectiveness of the antibiotic;(4) transformed E. coli with Kanamycin and IPTG to assess bacterial growth in the presence of colicins. By analyzing E. coli plasmid uptake, growth, and survival, we can add to existing research about colicin production in E. coli, and determine this specific E. coli strain’s capabilities of colicin production.
Keywords: Colicins, Escherichia coli, antibiotic resistance, foodborne illness
Authors are listed in alphabetical order. Alberto Donayre Torres and Matthew Kirkpatrick mentored the group. Please direct all correspondence to MKirkpatrick@oprfhs.org.
Background
E. coli is a common bacteria found in food, water, and the human gut. While mostly harmless, some strains can cause severe infections. Strains such as E. coli K-12 do not contain the toxin genes of stx1/stx, and are non-pathogenic (Cornell EHS, 2024), while strains such as the Shiga toxin-producing E. coli are very harmful to humans. An estimated 2,801,000 acute infections are caused annually worldwide by one of the most dangerous strains, Shiga toxin-producing E. coli, (Majowicz et al. 2014).Temkin et al. (2018) also explain that cephalosporin-resistant E. coli alone caused 50.1 million serious infections in 2014.
As antibiotic resistance rises, E. coli remains a significant public health threat. Rasheed et al. (2014) explain that the prevalence of drug resistance in E. coli taken from various food samples sourced in Indian localities was 14.7% in 2014. Resistance in E. coli is a result of gene mutations that allow resistant E. coli to survive antibiotics and pass their genes onto the next generation. This antibiotic resistance is also further spread throughout a population by conjugation, where an antibiotic-resistant E. coli will spread a plasmid to surrounding E. coli (Tao et al. 2022). Many measures to combat antibiotic resistance look at improving current antibiotics or developing new ones, but this study examines a different approach.
Colicins are toxic proteins endogenously produced by E. coli to eliminate competing bacterial strains by rapidly damaging the cell membrane. Studies suggest that colicins can supplement or replace antibiotics to combat resistant strains (Jin et al., 2021; Kamenšek & Žgur-Bertok, 2013). Furthermore, unlike traditional antibiotics, colicins target multiple cellular functions such as transport, diffusion, or efflux systems, making it more difficult for bacteria to develop resistance.
There is scant research in the existing literature covering how well colicins from E. coli K-12 can combat antibiotic resistance. So, our study examines the specific combination of our plasmid and the E. coli K-12 strain to assess whether colicins could be a viable tool in combating antibiotic resistance.
E. coli K-12 is commonly used as a model organism in genetics research. Experiments done on this strain can be replicated on other E. coli strains. We aim to successfully transform these bacteria with the plasmid we designed using heat shock transformation. If our experiment is successful, it will validate the ability of E. coli K-12 to uptake this plasmid, which codes for antibiotic resistance, colicin production, and colicin resistance.
Materials and Methods
Plasmid design
To test the efficacy of our bacterial transformation, we used E. coli K-12, which is a non-pathogenic strain. We designed a plasmid using SnapGene (Figure 1). For our plasmid design, we started with a pet28+ backbone with a Multiple Cloning Site, which had a built-in gene for kanamycin resistance to select for cells that were successfully transformed. Then, we used the BamHI and XhoI restriction sites to cut the plasmid and insert cvi and cvaC. Finally, our backbone contained an inducible T7 promoter that utilized IPTG for activation, allowing us to control when our genes were expressed.
Bacterial Transformation
We used four groups for our experiment; we plated our transformed bacteria on a plate with just food (LB). This was to test if we had viable bacteria to survive the transformation. On a second plate, we plated LB, transformed bacteria, and an antibiotic (Kanamycin). The third plate was LB, Kanamycin, and non-transformed bacteria. Finally, we plated LB, Kanamycin, our transformed bacteria, and IPTG. The expected and observed results are summarized in Table 1 at the bottom of the results section.
Results
In the plate with LB and transformed E. coli, we expected a lawn as there was nothing to kill the E. coli; the colicin is not automatically produced when the plasmid is successfully integrated into the bacteria, it must be activated (by ITPG). We saw a lawn, as expected, meaning that our E. coli is viable and can survive after being transformed by our plasmid. On the plate with agar, Kanamycin, and transformed E. coli, we expected colonies with our transformed bacteria, which we had selected for by implementing an antibiotic resistance gene in our plasmid. We saw colonies, meaning our plasmid was successfully integrated into some of the bacteria, allowing the transformed E. coli to survive the Kanamycin.
The plate with LB agar, Kanamycin, and non-transformed E. coli, tested whether our antibiotic could kill the bacteria, which if it could, would showno growth. We saw no growth, as expected, suggesting that our antibiotic can effectively kill non-resistant bacteria. Finally, to test if our E. coli produced the colicin or not when activated, we plated LB agar, Kanamycin, IPTG (0.1mM), and transformed E. coli. We saw no growth when we expected colonies. This leads us to conclude that the colicin is cytotoxic to the bacteria that produce it, and that our colicin immunity protein did not work.

|
|---|
Discussion
The five small colonies on our plate with the plasmid, antibiotics, and no activation suggest that the plasmid was transformed, however, it is possible that the cells had trouble proliferating. It is also possible that there is a low transformation rate and the E. coli do not efficiently uptake our plasmid. We used a heat shock transformation, which, as Lessard (2013) explains, is less efficient than other transformation methods such as electroporation. The plate with the plasmid, antibiotics, and the IPTG had no growth. This could suggest that the plasmid was transformed, but the colicin produced is cytotoxic, and our immunity protein was ineffective, so the colicin killed the bacteria that produced it. Our protein may have been ineffective because it did not fold properly, or there were metabolic burdens. In the future, we would take a look at our immunity protein and attempt to definitively figure out why it did not work well. This could give us insight into how to provide an effective method for preventing the death of transformed E. coli. We would also find a way not only to test whether colicins are produced, but whether they kill other bacteria. The methods we used previously only revealed whether or not the colicin was produced.
Next Steps
First, we will run experiments with LB Agar, non-transformed E. coli, and IPTG to show that IPTG does not have any cytotoxic effects. Then, we intend to conduct an experiment where we grow the transformed E. coli in a solution with only antibiotics, and add the IPTG only after we observe sufficient bacterial growth, allowing for the production of a significant quantity of colicins. We can then test the colicins for cytotoxic abilities. After testing whether or not the colicins produced are cytotoxic to other bacteria, we will conduct an experiment to confirm whether our colicin-producing transformed bacteria can inhibit the growth of environmental bacteria from samples taken in the local community. We can later expand the scope of this experiment to other communities, and we can target dangerous and prevalent E. coli such as Shiga toxin-producing E. coli or cephalosporin-resistant E. coli. We also intend to explore whether or not our colicin-producing E. coli can be incorporated into sanitization measures, where it could be used as a spray or disinfectant coating to kill harmful bacteria. In addition, we will assess the amount of colicin produced and the fitness cost to the bacteria resulting from colicin production.
Author Contributions
LZ: Identified colicins as an area of interest, contributed to research about colicins’ mechanisms and efficacy against treatment-resistant E. coli. KR: Contributed to research to determine bacteria of interest, transformed research into a lightning talk, developed the results table, and revised and organized the manuscript. AJL: Contributed to research to determine proteins available for use against E. coli, contributed to research about colicins’ mechanisms and efficacy against treatment-resistant E. coli, contributed to writing the abstract for the poster. AML: Contributed to research about the structure and function of colicins, helped write the background and the abstract, wrote the discussion section, and helped revise the manuscript. NK: Contributed to researching the use of bacteria and past trials, contributed to writing the abstract. RS: Designed the plasmid, organized the poster, and delegated and led the group. CS: Delegated and led the group, organized and revised the poster, and wrote the science content section. LL: Contributed to research into the backbone of the plasmid, helped develop the lightning talk, and contributed to the background research of colicins. GH: Contributed to research of colicin structure, made graphic for presentation. LN: Contributed to research about possible treatment methods and past usage of colicins and contributed to writing the abstract and background.
Acknowledgments
We would like to thank Alberto Donayre Torres at UTEC for his valuable guidance during our research process,and Twist Bioscience for manufacturing the plasmid used in our experiment. BioBuilder Educational Foundation made this project possible, giving us the opportunity to conduct our research. Finally, we would like to express our sincere gratitude to Matthew Kirkpatrick for sponsoring our project and for sharing his expertise to advise us.
References
Cornell Environment, Health and Safety (CEHS) (2024). Non-pathogenic Escherichia coli Strains Biological Agent Reference Sheet (BARS). https://www.cdc.gov/ecoli/about/kinds-of-ecoli.html
Housden, N. G., & Kleanthous, C. (2010). Methods in Enzymology (1st ed., Vol. 488). Elsevier. https://www.sciencedirect.com/science/article/abs/pii/B9780123812681000069
Jin, X., An, S., Kightlinger, W., Zhou, J., & Hong, S. H. (2021). Engineering Escherichia coli to produce and secrete colicins for rapid and selective biofilm cell killing. AIChE Journal. American Institute of Chemical Engineers, 67(12), e17466. https://doi.org/10.1002/aic.17466
Kamenšek, S., Žgur-Bertok, D. (2013). Global transcriptional responses to the bacteriocin colicin M in Escherichia coli. BMC Microbiology 13, 42. https://doi.org/10.1186/1471-2180-13-42
Lessard, J. C. (2013). Transformation of E. coli via electroporation. Methods Enzymol, 529, 321-327.
Majowicz, S. E., Scallan, E., Jones-Bitton, A., Sargeant, J. M., Stapleton, J., Angulo, F. J., Yeung, D. H., & Kirk, M. D. (2014). Global incidence of human Shiga toxin-producing Escherichia coli infections and deaths: A systematic review and knowledge synthesis. Foodborne Pathogens and Disease, 11(6), 447–455. https://doi.org/10.1089/fpd.2013.1704
Marković, K. G., Grujović, M. Ž., Koraćević, M. G., Nikodijević, D. D., Milutinović, M. G., Semedo-Lemsaddek, T., & Djilas, M. D. (2022). Colicins and microcins produced by Enterobacteriaceae: Characterization, mode of action, and putative applications. International Journal of Environmental Research and Public Health, 19(18), 11825.
Rasheed, M. U., Thajuddin, N., Ahamed, P., Teklemariam, Z., & Jamil, K. (2014). Antimicrobial drug resistance in strains of Escherichia coli isolated from food sources. Revista do Instituto de Medicina Tropical de Sao Paulo, 56(4), 341–346. https://doi.org/10.1590/s0036-46652014000400012
Tao, S., Chen, H., Li, N., Wang, T., & Liang, W. (2022). The spread of antibiotic resistance genes in vivo model. The Canadian Journal Of Infectious Diseases & Medical Microbiology = Journal canadien des maladies infectieuses et de la microbiologie medicale, 2022, 3348695. https://doi.org/10.1155/2022/3348695
Temkin, E., Fallach, N., Almagor, J., Gladstone, B. P., Tacconelli, E., Carmeli, Y.,et al. (2018). Estimating the number of infections caused by antibiotic-resistant Escherichia coli and Klebsiella pneumoniae in 2014: A modelling study. The Lancet. Global Health, 6(9), e969–e979. https://doi.org/10.1016/S2214-109X(18)30278-X